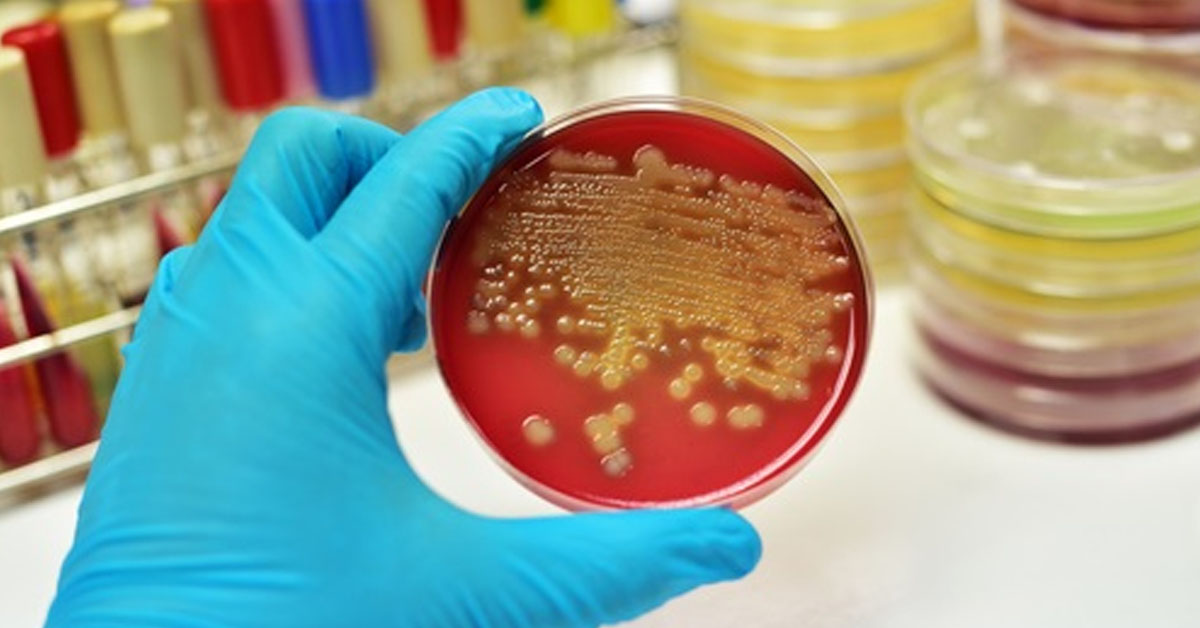

Все больше и больше людей работают таким образом, что они практически вынуждены оставаться сидящими большую часть дня, особенно те, кто работает в офисе.
Длительное сидение имеет разрушительные последствия как для здоровья, так и для увеличения размера талии, накопления жира и воспаления!
Но есть некоторые вещи, которые вы можете сделать, даже если вы находитесь в офисе или дома и проводите много времени сидя. Эти упражнения выполнять в кресле легко, но очень эффективно, чтобы получить плоский живот и активизировать кровообращение.
Упражнения на стуле для устранения жировых отложений на животе
Эти шесть упражнений может выполнять каждый, и, что самое приятное, вам даже не нужно вставать со стула.
1. От колена до груди
Сядьте, спина прямая и не касаясь спинки стула. Держите ноги на полу на ширине бедер. При выдохе поднимите правое колено к груди. Задержитесь на несколько секунд, прежде чем медленно выпустить ногу на пол во время выдоха. Теперь сделайте то же самое с левой ногой.

Повторите 20-30 раз с каждой ногой. Вы можете делать это 3-4 раза в неделю.
Это упражнение помогает вам сжигать жир, улучшает обмен веществ и укрепляет мышцы живота и поясницы. А также помогает растянуть ноги и сделать их более гибкими.
2. Двойной подъем колена
Вытяните спину и держите обе стороны стула руками. Затем одновременно прижмите оба колена к груди. Держите мышцы живота напряженными и медленно опускайте ноги, не касаясь земли, прежде чем поднимать их снова.
Повторите 10-20 раз.

Это упражнение работает мышцами живота эффективным, но мягким способом.
3. Двойной подъем колена с боковым вращением
Сядьте на край стула с прямой спиной. Держите стул крепко обеими руками и поднимите ноги ( оставляя ягодицы на краю стула). Держите колени и поднимите их к груди, затем опустите ноги, не касаясь земли, прежде чем снова поднять.
Повторите 10-20 раз с каждой стороны.

Это упражнение идеально подходит для тех, кто хочет уменьшить талию.
4. Наклоны
Держите ноги на полу и поднимите руки на уровне плеч. Затем поверните направо и потянитесь вперед, чтобы коснуться правой ноги левой рукой. Задержитесь в этом положении на несколько секунд, прежде чем вернуться в исходное положение. Затем сделайте то же самое движение на другой стороне.
Повторите 20-30 раз.

Это упражнение сжигает жир в области бедер и живота.
5. Боди-лифт
Это упражнение требует стабильного стула с подлокотниками. Крепко держите подлокотники, а затем вытяните руки, одновременно поднимая все тело с кресла, чтобы ваши ноги были в воздухе. Поднявшись, поднимите колени к груди и попытайтесь удержать положение в течение 15 секунд. Затем медленно опускайтесь и дышите.
Повторите четыре раза.

Это упражнение эффективно сжигает жир и дает вам хорошо настроенную спину, плечи и живот.
6. Колено до локтя
Сядьте на стул с прямой спиной, не касаясь спинки стула. Положите обе руки на затылок. Затем поднимите правое колено и попробуйте коснуться левого локтя. Вернитесь в исходное положение и повторите с левым коленом и правым локтем.
Сделайте четыре подхода по 15 подъемов с каждой стороны.

Это упражнение очень хорошо для вашего пресса. Просто убедитесь, что ваше колено касается локтя.
Эти упражнения легко выполнять и не занимают много времени. В дополнение к хорошему тонусу тела, вы будете чувствовать себя полным энергии в течение дня. Почему бы не начать тренироваться на работе и сэкономить время в тренажерном зале?
А также рекомендуем вам: 3 упражнения для идеально плоского живота, красивой осанки и устранения болей в спине
http://www.youtube.com/watch?v=Vdu8sR8G91E

настойка мухомора
настойка мухомора






































